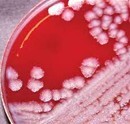
Decorative

CAP Survey: LPX-A
 Bacillus cereus var. anthracis culture
Bacillus cereus var. anthracis culture
 B. cereus var. anthracis gram stain
B. cereus var. anthracis gram stain
CAP Survey: LPX-A are going to be shipped on March 30, 2026.
- Participating Sentinel Laboratories will be shipped a CAP LPX-A Survey soon. Listed below is some important information to assist you in ruling out possible Select Agents as well as sending in one isolate. This is part of the Packaging and Shipping Exercise component of the preparedness grant. The isolate is one that you can NOT rule out as a select agent.
- Refer to LRN Sentinel Level Clinical Laboratory Protocols (asm.org) for Sentinel Laboratory guidelines.
- These organisms are intended to have rule-out identifications performed with limited biochemicals as described in the LRN Protocols.
- The use of automated systems is highly discouraged due to the potential risk of lab exposure by aerosolization and erroneous identification.
- The test specimens must be subbed TWICE to plate media prior to initiating guideline testing in order to ensure a metabolically robust organism ready for testing.
- CAP requires the following dates to be noted on the answer sheet:
- The date the specimen was set up (initial plating).
- The date that the guideline testing was initiated.
- The date guideline testing was completed.
- The date you called the MTPHL concerning the discovery of an organism that could NOT be ruled out as a Select Agent.
-
CALL BEFORE SENDING CULTURES TO THE STATE!!! Call (800)821-7284 (MTPHL) or (406)444-5251 (Microbiology).
- Properly complete an online order for each culture submitted. Select the Biothreat Organism Screen from the list (Abbreviation “Bio Threat S”). One culture and one requisition form per biohazard bag please.
- Do not send patient specimens/isolates with LPX cultures. The patient specimens will not be processed.
- Cultures should be triple packaged (primary container sealed with parafilm; leakproof secondary container with absorbent material and marked with biohazard symbol; rigid outer container with proper address and proper UN label depending on whether you are sending the culture as a Category A or B agent) and marked with “LPX EXERCISE” on the outside of the outer container.
- Any culture must be shipped as a UN3373 or UN2814 regardless of it arriving by courier. The choice of the shipping category is dependent upon how your facility wishes the packaging to be evaluated and whether personnel are trained and certified to ship Category A (UN2814) packages.
- We will evaluate your packaging and your shipping documentation. We do not evaluate your culture results.
- Refer to your 2024 LPX-B packaging and shipping letter and check list for guidance on problematic areas.
 Bacillus cereus var. anthracis culture
Bacillus cereus var. anthracis culture Bacillus cereus var. anthracis culture
Bacillus cereus var. anthracis culture B. cereus var. anthracis gram stain
B. cereus var. anthracis gram stain